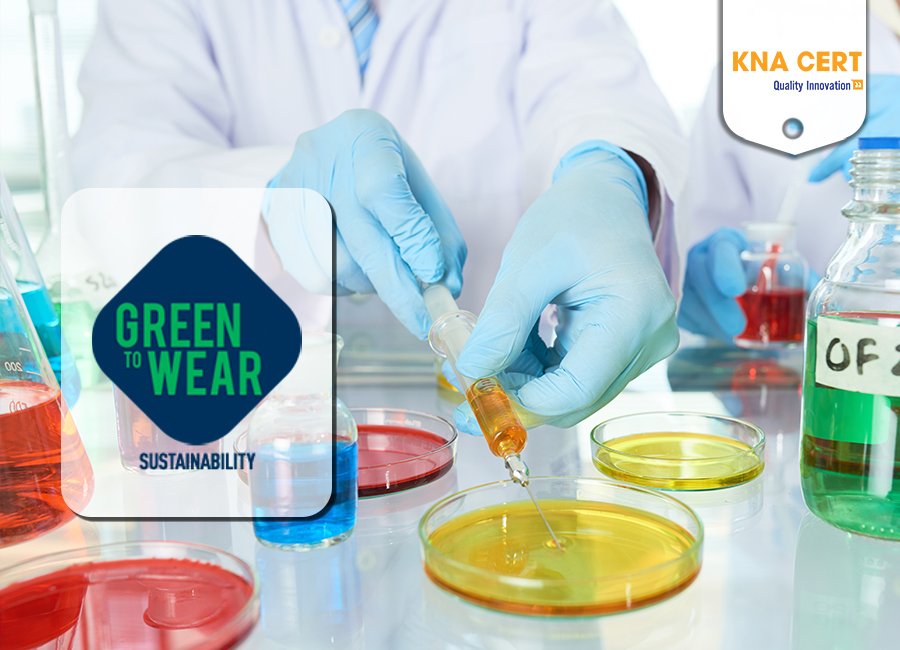

Tiêu chuẩn Green To Wear của Inditex cho ngành may mặc
Green To Wear (GTW) là của là tiêu chuẩn quản lý hóa chất và môi trường xanh của Tập đoàn Inditex. KNA CERT cung cấp dịch vụ Đánh giá Tiêu chuẩn nhãn hàng Inditex theo các quy định của Green To Wear cho tất cả các tổ chức, doanh nghiệp là đối tác kinh doanh, nhà cung cấp của Inditex.

GIỚI THIỆU VỀ TẬP ĐOÀN INDITEX
Inditex (Industria de Diseño Textil, S.A.) là công ty sản xuất quần áo đa quốc gia có trụ sở tại thành phố Arteixo, A Coruña trong vùng Galicia ở Tây Ban Nha. Inditex là tập đoàn thời trang lớn nhất Thế giới với hệ thống 7,200 cửa hàng ở 93 quốc gia và vùng lãnh thổ.
Thương hiệu chính của tập đoàn là Zara, bên cạnh các nhãn hàng khác như Zara Home, Massimo Dutti, Bershka, Oysho, Pull and Bear, Stradivarius, và Uterqüe. Hầu hết các cửa hàng của Inditex thuộc quyền sở hữu trực tiếp của tập đoàn. Ở vài quốc gia không cho phép sở hữu ngoại quốc thì các cửa hàng được mở theo hình thức nhượng quyền.
GREEN TO WEAR LÀ GÌ?
1. Tiêu chuẩn Green To Wear là gì?
Green To Wear (viết tắt là GTW) là tiêu chuẩn để có được một sản phẩm dệt may hoặc da giày bảo vệ sức khỏe của người tiêu dùng. Green To Wear được ra đời và phát triển bởi Tập đoàn Inditex nhằm tuân thủ luật pháp về an toàn sản phẩm và sức khỏe con người nghiêm ngặt nhất. Green To Wear hạn chế một số hóa chất độc hại hoặc, nếu có, không vượt quá giới hạn đã đặt ra.
2. Phiên bản mới nhất của Tiêu chuẩn GTW
Inditex phát hành phiên bản 2.1 của Tiêu chuẩn Green To Wear (GTW) vào tháng 9 năm 2023. Đây là phiên bản mới nhất tính tới thời điểm hiện tại của tiêu chuẩn này.
ĐỐI TƯỢNG CỦA TIÊU CHUẨN GREEN TO WEAR (GTW)
Tiêu chuẩn Green To Wear được áp dụng cho các sản phẩm quần áo, giày dép, phụ kiện và/hoặc vải cung cấp cho Tập đoàn Inditex. Điều này đồng nghĩa với việc tất cả các đối tác kinh doanh, nhà cung cấp cung ứng các sản phẩm trên cho Inditex đều phải tuân thủ Tiêu chuẩn Green To Wear.

NỘI DUNG TIÊU CHUẨN GREEN TO WEAR 2.1
1. Giới thiệu
2. Quy trình sản xuất bị ảnh hưởng bởi Tiêu chuẩn Green To Wear
Bảng I: Các quy trình sản xuất có trong tiêu chuẩn bền vững Green to Wear
3. Chiến lược kiểm soát hóa chất Inditex
4. Chương trình Chăm sóc Nước (Care For Water Program)
4.1. Yêu cầu để có được dấu CFW
4.2. Tính toán lượng nước tiêu thụ
4.3. Quy trình sản xuất nằm ngoài chương trình Chăm sóc nước
5. Chương trình Chăm sóc hành tinh (Care For Planet Program)
5.1. Yêu cầu để có được dấu CFP
6. Phân tích nội bộ
6.1. Truy xuất nguồn gốc
6.2. Yêu cầu tuân thủ
6.3. Tương quan
6.4. Tần suất kiểm tra độ pH
6.5. Tần suất kiểm tra độ bền màu
7. Thực hành sản xuất được khuyến nghị
7.1. Các tài liệu
7.2. Hàng tồn kho
7.3. Kho chứa hóa chất
7.4. Truy xuất nguồn gốc quá trình sản xuất
7.5. Khuyến nghị cho sản phẩm dành cho trẻ em
7.6. Biến quá trình dệt
7.7. Biến quá trình da. Khuyến nghị Crôm VI
7.8. Những điểm chính để sản xuất hàng dệt và da không chứa PFAS
8. GTW 2.1 Hồ sơ đánh giá
8.1. Quy trình đánh giá
8.2. Tài liệu đánh giá
8.3. Yêu cầu pháp lý
8.4. Sự tiêu thụ nước
8,5. Chất thải rắn
8.6. Tiêu thụ năng lượng
8.7. Thông tin khác
Phụ lục
A1. Đánh giá rủi ro của sản phẩm hóa chất. Nhà máy dệt (1/2)
A1. Đánh giá rủi ro của sản phẩm hóa chất. Nhà máy dệt (2/2)
A2. Đánh giá rủi ro của sản phẩm hóa chất. Nhà máy da
A3. Đánh giá rủi ro chi tiết của sản phẩm hóa chất. Nhà máy dệt
A4. Đánh giá rủi ro chi tiết của sản phẩm hóa chất. Nhà máy da
A5. Tiêu chí đánh giá cuối cùng của hóa chất
A6. Giới hạn tiêu thụ nước
A7. Phân tích trong nhà. Thiết bị cần thiết
LỢI ÍCH KHI TUÂN THỦ TIÊU CHUẨN GREEN TO WEAR
- Có cơ hội trở thành Nhà cung cấp của Inditex
- Tuân thủ pháp luật quốc gia và Quốc tế về Quản lý hóa chất và Môi trường
- Quản lý tốt các nguồn rủi ro cao và có biện pháp phòng tránh
- Nâng cao chất lượng và an toàn sản phẩm
- Giảm chi phí xử lý sự cố
- Tăng trưởng doanh thu
- Được Khách hàng và Đối tác tin tưởng lựa chọn
- Nâng cao năng lực cạnh tranh trên thị trường
- Xóa bỏ rào cản xuất khẩu hàng hóa sang các khu vực như: Mỹ, Châu Âu, Anh….
QUY TRÌNH ĐÁNH GIÁ GREEN TO WEAR
Bước 1: Tìm hiểu và thực hiện các yêu cầu của Tiêu chuẩn Green To Wear
Doanh nghiệp hãy tìm hiểu nội dung của Tiêu chuẩn GTW. Nó sẽ bao gồm tất cả các yêu cầu mà hoạt động của doanh nghiệp sẽ được đánh giá. Kế đó cần triển khai thực hiện Tiêu chuẩn, đảm bảo sự tuân thủ theo các chính sách. Doanh nghiệp có thể tổ chức các khóa đào tạo cho nhân sự để áp dụng Tiêu chuẩn hiệu quả hơn.
Bước 2: Lựa chọn Tổ chức đánh giá & Đăng ký Đánh giá
Doanh nghiệp phải đảm bảo chọn được Tổ chức đánh giá được phê duyệt để thực hiện đánh giá theo yêu cầu của GTW. Sau đó tiến hành khai báo thông tin theo yêu cầu của Tổ chức đánh giá để đăng ký đánh giá.
Bước 3: Chuẩn bị đánh giá
Doanh nghiệp ký kết hợp đồng xác nhận việc đồng ý đánh giá với Tổ chức đánh giá và chuẩn bị cho đánh giá chính thức. Đánh giá viên sẽ có cuộc họp đầu tiên với ban quản lý nhà máy.
Bước 4: Đánh giá chính thức
Tổ chức đánh giá tiến hành đánh giá thực tế tại Doanh nghiệp, trong đó thực hiện các hoạt động:
- Tham quan nhà máy: Đánh giá viên kiểm soát khu vực làm việc, bàn làm việc, khu vực xã hội, nhà vệ sinh, nhà kho, ...
- Phỏng vấn: Đánh giá viên nói chuyện với các nhân viên được chọn ngẫu nhiên mà không có sự hiện diện của quản lý, một số trường hợp sẽ có đại diện nhân viên
Bước 5: Thẩm xét hồ sơ, tài liệu, quy trình
Đánh giá viên kiểm tra các tài liệu: hồ sơ nhân sự, bảng lương, đóng góp an sinh xã hội, ...
Bước 6: Hành động khắc phục
Doanh nghiệp phải tiến hành hành động khắc phục trong thời gian quy định và báo cáo lại cho Tổ chức chứng nhận để sửa chữa những điểm chưa tuân thủ (nếu có).
Bước 7: Xếp hạng nhà cung cấp
Inditex sẽ dựa vào kết quả đánh giá để xếp hạng doanh nghiệp theo A (tốt nhất), B, C hoặc D
Bước 8: Tái đánh giá
Hiệu lực đánh giá phụ thuộc vào yêu cầu của Inditex. Quy trình tái đánh giá tương tự như các bước trên.
KNA CERT CUNG CẤP DỊCH VỤ ĐÁNH GIÁ GREEN TO WEAR
1. Xếp hạng Nhà cung cấp của Inditex
Xếp hạng Nhà cung cấp của Inditex là bằng chứng chứng minh mức độn tuân thủ tiêu chuẩn doanh nghiệp đã hoàn thành cuộc đánh giá chính thức và phản ánh mức độ tuân thủ Green To Wear của doanh nghiệp.
Có 4 loại xếp hạng Nhà cung cấp từ thấp đến cao được chia thành:
Xếp hạng D - Cơ sở vật chất không được phê duyệt cho sản phẩm của Inditex
Các nhà máy được xếp hạng "D" khi có ít nhất một trong các điều kiện không tuân thủ sau đây:
| Kiểm soát tuân thủ và phát thải | 1. Nhà máy bị phạt 2 khoản tiền phạt về môi trường trở lên trong hai năm qua. |
| 2. Nhà máy đốt chất thải trong cơ sở của mình mà không được phép. Nhà máy đốt chất thải dệt may dù có hoặc không có sự cho phép. | |
| 3. Nhà máy không có giấy phép tiêu thụ tất cả nguồn nước của mình. | |
| 4. Nhà máy không được cấp phép xả thải nước | |
| 5. Nhà máy đốt than/bùn/dầu diesel/dầu đốt bằng bộ lọc không kiểm soát khí thải và không đáp ứng giới hạn cho phép. | |
| Nước thải | 6. Chưa có Nhà máy xử lý nước thải (bên trong và/hoặc bên ngoài) để xử lý nước thải đã qua xử lý trước khi thải trực tiếp ra môi trường. |
| 7. Nhà máy xử lý nước thải không xử lý đúng 100% nước thải đã xử lý (không bao gồm thất thoát như nước thải đã xử lý bay hơi): không có biện pháp xử lý nước thải phù hợp cũng như quy mô không đủ để có thể xử lý 100% nước thải đã xử lý của nhà máy. | |
| Thuốc tím dành cho vải denim | 8. Nếu nhà máy đang sử dụng thuốc tím mà không có một trong hai hệ thống bảo vệ này: mở cabin bằng vòi phun hoặc thác nước để thu hồi thuốc tím, VÀ/HOẶC không có hệ thống sục khí thích hợp. Xin lưu ý rằng thuốc tím sẽ sớm bị hạn chế đối với sản phẩm của Inditex vào ngày được xác định. |
| DMF cho PU | 9. Nếu DiMethylFormamide (DMF) đang được sử dụng trong đơn vị sản xuất mà máy nghiền không có thiết bị thu gom. DMF cũng sẽ sớm bị hạn chế đối với các sản phẩm của Inditex vào ngày được xác định. |
| Quản lý hóa chất | 10. Nhà máy không có kho lưu trữ các sản phẩm hóa chất được sử dụng trong quá trình sản xuất. |
| 11. Dưới 20% sản phẩm hóa chất được kiểm soát theo chiến lược do Inditex xác định hoặc Báo cáo Kiểm tra Hiệu suất đã được xác minh cho thấy dưới 20% sản phẩm hóa chất tuân thủ ZDHC cấp 3. | |
| 12. Có những sản phẩm hóa chất được sử dụng trong sản xuất của INDITEX được phân loại là “C” trong ấn bản hiện tại của “Danh sách của Inditex”. | |
| 13. Có những sản phẩm hóa chất được sử dụng trong công thức quy trình sản xuất (nằm ngoài phiên bản hiện tại của “Danh sách của Inditex” hoặc Cấp 3 của ZDHC Gateway) có kết quả kiểm tra vượt quá giới hạn hạn chế của Inditex. | |
| 14. Sản phẩm hóa chất lưu giữ tại nhà máy không được đăng ký vào kho hóa chất. | |
| Phòng ngừa crom VI | 15. Xưởng thuộc da không kiểm soát rủi ro crom (VI) liên quan đến việc sử dụng chất béo. |
Xếp hạng C - Cơ sở được phê duyệt cho sản xuất của Inditex với kế hoạch hành động khắc phục (1/2)
Các nhà máy được xếp hạng là "C" khi có ít nhất một trong các điều kiện không tuân thủ sau đây:
| Kiểm soát tuân thủ và phát thải | 1. Việc xả nước thải vượt quá giới hạn pháp lý đối với bất kỳ thông số nào (theo mẫu nước do INDITEX thực hiện theo Hướng dẫn về nước thải của ZDHC). Xem thêm “Hướng dẫn về nước thải ZDHC”: https://downloads.roadmaptozero.com/output/ZDHC-Wastewater-Guidelines |
| 2. Nhà máy đã không tiết lộ kết quả xử lý nước thải của mình trên nền tảng công cộng, không thải hóa chất độc hại sau khi kiểm tra GTW. | |
| 3. Việc xả thải gián tiếp vượt quá giới hạn áp dụng (bao gồm cả giới hạn đã thỏa thuận với Nhà máy xử lý nước thải bên ngoài). | |
| Mức tiêu thụ | 4. Nhà máy không ghi lại mức tiêu thụ nước và năng lượng hàng tháng. |
| Tiết kiệm nước | 5. Nhà máy không sử dụng đồng hồ đo lưu lượng để theo dõi lượng nước tiêu thụ và/hoặc tổng lượng nước thải. |
| 6. Nhà máy không có đồng hồ đo mực nước/bộ điều khiển đồng hồ đo lưu lượng nước dùng cho thiết bị giặt, nhuộm và thùng trộn. | |
| 7. Nhà máy nhuộm thải sử dụng máy nhuộm tời kém hiệu quả với tỷ lệ dung dịch > 1:7. (ít nhất 80% sản lượng không được đến từ máy nhuộm có tỷ lệ dung dịch > 1:7). | |
| 8. Nhà máy không tái sử dụng nước ngưng của lò hơi. | |
| 9. Nhà máy không tái sử dụng nước làm mát không tiếp xúc từ tất cả các máy móc (không bao gồm các thiết bị rửa tinh khiết). | |
| Hiệu suất năng lượng | 10. Nhà máy đang đốt than, dầu diesel hoặc dầu nhiên liệu, bất chấp thực tế là địa phương có sẵn khí đốt tự nhiên, propan hoặc sinh khối (được chứng nhận FSC hoặc từ chất thải nông nghiệp) và năng lượng tái tạo khác. |
| 11. Ít hơn 80% ống hơi và ống ngưng tụ được cách nhiệt. | |
| 12. Việc rò rỉ hơi nước và nước không được giám sát và kiểm tra thường xuyên. | |
| Nước thải | 13. Nước thải không được xử lý tối thiểu qua xử lý sinh học hoặc vật lý hóa học + lọc tốc độ cao trước khi thải ra môi trường (không bao gồm các đơn vị rửa tinh khiết). |
| 14. Nước thải được thải vào Nhà máy xử lý nước thải thành phố mà không qua xử lý trước tại nhà máy (không bao gồm các thiết bị rửa tinh khiết) | |
| 15. Nhà máy không kiểm tra nước thải bên trong hoặc bên ngoài (ít nhất là phân tích hàng quý về Nhu cầu Oxy Hóa học (COD) | |
| 16. Nồng độ của các chất MRSL có trong Hướng dẫn về Nước thải ZDHC là =/> 0,1 ppm (ngoại trừ Thuốc nhuộm – Chất gây ung thư hoặc mối lo ngại tương đương và Thuốc nhuộm – Chất tạo màu xanh hải quân, có nồng độ =/>0,5 ppm). | |
| Quản lý hóa chất | 17. Nhà máy không lưu giữ hồ sơ về quy trình sản xuất, hóa chất được sử dụng hoặc số lượng (không có công thức sản xuất). |
| 18. Dưới 60% sản phẩm hóa chất được kiểm soát theo chiến lược do Inditex xác định hoặc Báo cáo Kiểm tra Hiệu suất đã được xác minh cho thấy dưới 60% sản phẩm hóa chất tuân thủ ZDHC cấp 3. | |
| Phòng ngừa crom VI | 19. Xưởng thuộc da không thực hiện quy trình tẩy nhờn bằng cách sử dụng sản phẩm được đăng ký chính xác làm chất tẩy nhờn trong TDS. |
| 20. Không có sổ đăng ký đo pH của bể ngâm cuối cùng cho từng lô da được sản xuất. Trong trường hợp không có thông tin về điểm này, hãy đăng ký độ pH của da cho từng lô sản xuất. | |
| 21. Da được thải ra và bảo quản bên ngoài thùng giặt ở độ pH trong bể trên 6,0. | |
| 22. Giá trị pH của da thành phẩm không nằm trong khoảng 3,2 đến 4,0 như được đo theo ISO 4045. |
Xếp hạng B - Cơ sở vật chất được phê duyệt cho sản xuất của Inditex (1/2)
Các nhà máy được xếp hạng "B" khi có ít nhất một trong các điều kiện không tuân thủ sau đây:
| Kiểm soát khí thải | 1. Khí thải từ quá trình đốt cháy không được giám sát, kiểm tra và không tuân thủ các giới hạn pháp lý. Khí thải từ hệ thống xả của nồi hơi cũng như các nguồn phát thải khác (ví dụ: ống đỡ, máy trộn, buồng xử lý). |
| Mức tiêu thụ | 2. Nhà máy không mua và tiêu thụ năng lượng xanh từ các nguồn tài nguyên tái tạo và được tạo ra từ bên ngoài |
| 3. Nhà máy không đạt mức Xuất sắc về lượng nước tiêu thụ bình quân hàng năm. | |
| 4. Nhà máy không có kế hoạch hành động được thiết kế để giảm lượng khí thải carbon và mức tiêu thụ năng lượng, theo lộ trình mục tiêu giảm 1,5°C do IPCC xác định | |
| Hiệu suất năng lượng | 5. Tất cả các bể chứa và tất cả các đường ống nước nóng đều không được cách nhiệt (trừ những ống được chôn dưới lòng đất). |
| Nước thải | 6. Nhà máy không phân tích hàng tháng, Nhà máy xử lý nước thải đối với cả nước vào và nước ra đối với ít nhất 4 thông số: COD, BOD, pH &TSS (nội bộ hoặc bên thứ 3/chính phủ). |
| 7. Việc lấy mẫu nước không đáp ứng các giới hạn báo cáo của Hướng dẫn về Nước thải Không Xả thải Hóa chất Độc hại. | |
| 8. Việc lấy mẫu nước không đáp ứng các Thông số Nước thải Toàn cầu và kim loại nặng ở mức Cơ bản theo Hướng dẫn về Nước thải của ZDHC. | |
| Chất thải rắn | 9. Chất thải sợi dệt và sợi nhỏ được tạo ra trong các quy trình, chẳng hạn như nhưng không giới hạn ở quy trình bó, chải và cắt, không được xử lý như chất thải rắn cũng như không được tái sử dụng hoặc quản lý có trách nhiệm theo luật hiện hành. |
| 10. Nhà máy không có kho chất thải nguy hại và không gửi chất thải này đến đại lý được ủy quyền. Chất thải không được quản lý đúng cách (phân loại, dán nhãn, cách ly, thông gió và ngăn chặn rò rỉ). | |
| Quản lý hóa chất | 11. Dưới 100% sản phẩm hóa chất được kiểm soát theo chiến lược do Inditex xác định hoặc Báo cáo Kiểm tra Hiệu suất đã được xác minh cho thấy dưới 100% sản phẩm hóa chất tuân thủ ZDHC cấp 3. |
| 12. Nhà máy không có quy trình giải quyết lỗi được tuân thủ trong trường hợp thử nghiệm RSL không thành công. | |
| 13. Nhà máy không có sổ đăng ký hàng tháng về lượng sản phẩm hóa chất được sử dụng trong quá trình sản xuất được lưu giữ. | |
| 14. Bản kiểm kê hóa chất không bao gồm các thông tin bổ sung: chức năng hóa học, ngày đến, địa điểm lưu trữ, phân loại theo phiên bản hiện tại của “Danh sách theo Inditex” và cấp 3 của Môđun hóa chất ZDHC khi áp dụng. | |
| 15. Không có sẵn Bảng dữ liệu kỹ thuật (TDS) và Bảng dữ liệu an toàn (SDS) cho tất cả các hóa chất được đăng ký trong kho. | |
| 16. Danh mục sản phẩm hóa chất không bao gồm số lô của tất cả các hóa chất nằm ngoài phiên bản hiện tại của “Danh sách của Inditex” hoặc không có trong Cấp 3 của ZDHC Gateway. | |
| Yêu cầu sản xuất | 17. Công thức sản xất và đơn đặt hàng nội bộ không thể truy nguyên được đối với đơn đặt hàng của khách hàng. |
| 18. Các công thức sản xuất không thể truy nguyên được đối với các sản phẩm đã hoàn thiện. | |
| 19. Độ pH và độ bền màu của quần áo/vải/chất nền da không được kiểm tra nội bộ theo hướng dẫn của Inditex (thiết bị phù hợp, quản lý sổ đăng ký chính xác, tần suất kiểm tra chính xác và truy xuất nguồn gốc, kiểm tra tương quan hàng tháng với các phòng thử nghiệm được chứng nhận bên ngoài và kết quả được xác định dung sai). | |
| 20. Không có quy trình nội bộ nào để thông báo và xử lý lại lô không tuân thủ độ pH hoặc không tuân thủ độ bền màu (trong trường hợp kết quả kiểm tra không phù hợp với Yêu cầu Kiểm tra Vật lý (PTR). | |
| Quản lý bền vững | 21. Nhà máy không có người được chỉ định có kiến thức đúng đắn về chính sách bền vững của Inditex |
| Phòng ngừa crom VI | 22. Xưởng thuộc da không áp dụng bất kỳ biện pháp xử lý bảo vệ chống oxy hóa bổ sung nào. |
Xếp hạng A - Tốt nhất trong các cấp độ
Các nhà máy được xếp hạng "A" khi họ không có bất kỳ vấn đề nào không tuân thủ như trong hạng D, C hoặc B.
2. Dịch vụ Đánh giá Green To Wear theo yêu cầu của Inditex
KNA CERT cung cấp dịch vụ thử nghiệm và đánh giá Green To Wear theo yêu cầu của Inditex cho tất cả các tổ chức, doanh nghiệp trong ngành dệt may và da giày
KNA CERT cam kết về chất lượng dịch vụ:
- Quy trình làm việc Khoa học – Chuyên nghiệp
- Thủ tục tinh giản – Đảm bảo tiến độ
- Báo phí hợp lý – Không phát sinh chi phí
- Hỗ trợ 24/7 – Tận tâm – Trách Nhiệm
- Chính sách hậu mãi siêu tốt – Kèm nhiều ưu đãi hấp dẫn
Hãy liên hệ với KNA CERT ngay hôm nay để tìm hiểu chi tiết về Dịch vụ Đánh giá Tiêu chuẩn H&M và nhận báo giá ưu đãi mới nhất năm 2024
- Trụ sở chính: Tầng 11, Tòa nhà Ladeco Building, 266 Đội Cấn, Ba Đình, Hà Nội
- Chi nhánh: Tầng 7, Tòa nhà Thủy Lợi 4, 205A Nguyễn Xí, Phường 26, Quận Bình Thạnh, TPHCM
- Facebook: https://www.facebook.com/KNACertification
- Hotline: 0983.246.419/ 0981.222.786
- Email: salesmanager@knacert.com
Tin Mới Nhất

Chứng nhận ISO/IEC 27018: Bảo vệ thông tin nhận cá nhân (PII) trong điện toán đám mây công cộng
ISO/IEC 27018 là tiêu chuẩn quốc tế hướng dẫn các nhà cung cấp dịch vụ đám mây công cộng bảo vệ thông tin nhận dạng cá nhân (PII) một cách an toàn, minh bạch và có trách nhiệm. Khi điện...

Doanh nghiệp niêm yết và bài toán minh bạch dữ liệu ESG
Cuộc Bình chọn Doanh nghiệp Niêm yết 2026 chính thức khởi động, với báo cáo phát triển bền vững được nhấn mạnh là hạng mục trọng tâm bên cạnh báo cáo thường niên và quản trị công ty. Đây không...

ISO 3834-4: Tiêu chuẩn yêu cầu chất lượng cơ bản đối với hàn nóng chảy kim loại
Tiêu chuẩn ISO 3834-4 là mức yêu cầu chất lượng thấp nhất trong ba mức chứng nhận của bộ tiêu chuẩn ISO 3834 dành cho hàn nóng chảy vật liệu kim loại. Dù là mức cơ bản, ISO 3834-4 vẫn...

ISO 3834-3: Tiêu chuẩn yêu cầu chất lượng tiêu chuẩn đối với hàn nóng chảy kim loại
Tiêu chuẩn ISO 3834-3 — "Yêu cầu chất lượng tiêu chuẩn cho hàn nóng chảy vật liệu kim loại" — là mức độ chứng nhận trung bình trong bộ tiêu chuẩn ISO 3834, nằm giữa mức toàn diện (ISO 3834-2)...

ISO 3834-2: Các yêu cầu chất lượng toàn diện đối với hàn nóng chảy vật liệu kim loại
Tiêu chuẩn ISO 3834-2 được xem là cấp độ cao nhất và khắt khe nhất trong bộ tiêu chuẩn quốc tế về quản lý chất lượng hàn nóng chảy vật liệu kim loại ISO 3834. Đối với các doanh nghiệp...

SBTi V2.0 chính thức ban hành – Có điểm gì mới?
SBTi V2.0 — phiên bản cập nhật toàn diện nhất của Tiêu chuẩn Net-Zero Doanh nghiệp — đã chính thức được công bố vào ngày 11 tháng 6 năm 2026, đánh dấu bước ngoặt quan trọng trong hành trình khử...






